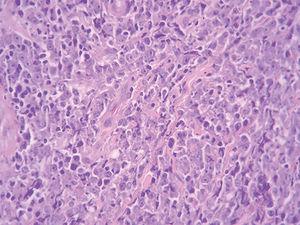

INTRODUCCION
Los linfomas primarios cutáneos de células B (LPCB) constituyen un grupo heterogéneo de linfomas no hodgkiniano de la piel sin evidencia de enfermedad extracutánea en el momento del diagnóstico 1. Suponen el 20-25 % del total de los linfomas cutáneos, y por lo general, tienen un comportamiento clínico indolente. Las recurrencias cutáneas no son excepcionales y sólo ocasionalmente puede observarse el desarrollo de enfermedad extracutánea 2,3.
Los linfomas primarios cutáneos han sido durante los últimos años un tema importante de debate y confusión. Tanto la clasificación de la Organización Mundial de la Salud (OMS) como la clasificación de la Organización Europea para la Investigación y Tratamiento del Cáncer (EORTC) han intentado agruparlos en múltiples ocasiones. Sin embargo, ambos sistemas de clasificación difieren entre sí en determinadas entidades, mostrando deficiencias significativas. Por fin, durante las reuniones de consenso más recientes celebradas en Lyon (septiembre 2003) y Zurich (enero 2004), ambos grupos unificaron sus criterios elaborando una nueva clasificación, denominada clasificación de la OMS-EORTC de los linfomas cutáneos 1.
En los últimos años, el intento de dividir los linfomas primarios cutáneos B de células del centro folicular (LPCCF) y los linfomas primarios cutáneos B de célula grande localizados en las piernas (LPCDP) ha sido muy debatido. Sin embargo, la nueva clasificación de la OMS-EORTC de los linfomas cutáneos reconoce los LPCDP como una entidad propia, separada de los LPCCF (tabla 1).
CASO 1
Una mujer de 83 años, con antecedentes personales de hipertensión, diabetes mellitus tipo 2 y cardiopatía isquémica, multimedicada consultó por la aparición de una lesión cutánea asintomática localizada en pierna izquierda de 4 meses de evolución. A la exploración física mostró un nódulo rojo violáceo de 3 cm de diámetro, bien delimitado, de consistencia dura e infiltrado al tacto (fig. 1). No se palpaban adenopatías ni visceromegalias. Se practicó una biopsia, con la que se observó una epidermis respetada y en la dermis un infiltrado celular denso y difuso que ocupaba toda la dermis y se extendía hasta el tejido celular subcutáneo (fig. 2). A mayor aumento, este infiltrado estaba compuesto principalmente por células atípicas grandes redondeadas (centroblastos) (fig. 3). Mediante técnicas inmunohistoquímicas, las células grandes fueron positivas para CD20 y CD79a, e intensamente positivas para bcl-2. El CD3 fue negativo. No se realizó reordenamiento genético. Las determinaciones analíticas (hemograma, velocidad de sedimentación globular [VSG], bioquímica, β2-microglobulina, lactato deshidrogenasa [LDH]), la tomografía computarizada (TC) toracoabdominal y el aspirado de médula ósea descartaron afectación sistémica.
Fig. 1.--Lesión tumoral eritematoviolácea infiltrada.
Fig. 2.--Epidermis conservada, zona grenz evidente y un infiltrado celular difuso dérmico que alcanza tejido subcutáneo. (Hematoxilina-eosina, x10.)
Fig. 3.--Abundantes células atípicas grandes redondeadas (centroblastos). (Hematoxilina-eosina, x40.)
La paciente recibió tratamiento con radioterapia de electrones localizada (40 Gy con un margen de 2 cm) y presentó recidiva local a los 3 meses de iniciado el tratamiento. Por tanto, y dadas la edad y la patología de base de la paciente, se inició tratamiento con anticuerpos anti-CD20 (375 mg/m 2/semanal x 4 semanas). La paciente permaneció asintomática durante 15 meses, momento en el que acudió a consulta con una nueva recidiva local acompañada de pérdida de peso, decaimiento y malestar general. Se ingresó a la enferma para estudio y nuevo estadiaje, pero falleció a los pocos días.
CASO 2
Un varón de 48 años, sin antecedentes personales de interés, consultó por la aparición, desde hacía un año y medio, de lesiones cutáneas localizadas en pierna derecha acompañadas de leve prurito que habían sido tratadas con corticoides potentes tópicos (clobetasol) sin mejoría. A la exploración física se observaron en cara anterointerna de pierna derecha 2 nódulos eritematosos de 1,5 y 1 cm de diámetro respectivamente, mal delimitados, infiltrados al tacto (fig. 4). No se palpaban adenopatías ni visceromegalias.
Fig. 4.--Nódulos eritematosos infiltrados, mal delimitados.
El estudio histológico, al igual que en el caso anterior, puso de manifiesto una epidermis conservada, y en la dermis un infiltrado celular difuso y denso que ocupaba toda la dermis, llegando al tejido celular subcutáneo y respetando una estrecha banda dérmica adyacente a la epidermis. Este infiltrado estaba formado por células atípicas grandes redondeadas (centroblastos) acompañadas de pequeñas células mononucleares. El estudio inmunohistoquímico identificó células B neoplásicas que fueron CD20 y CD79a positivas, y muy positivas para bcl-2. El CD3 resultó negativo. Se observó monoclonalidad para la cadena λ.
El estudio de extensión (hemograma, VSG, bioquímica, β2-microglobulina, LDH), la TC toracoabdominopélvica y la biopsia de la médula ósea fueron normales. El reordenamiento de las cadenas pesadas de las inmunoglobulinas fue policlonal.
Se realizó tratamiento con cirugía escisional y radioterapia de electrones localizada (40 Gy con un margen de 2 cm). El paciente no ha presentado recidiva después de 3 años de seguimiento.
DISCUSION
A partir de la década de 1980, tras la introducción de las técnicas inmunohistoquímicas, se produjo un incremento en el número de publicaciones sobre linfomas cutáneos primarios de células B en la literatura médica. Desde entonces ha habido múltiples intentos de clasificarlos y definirlos, tanto por el grupo de la REAL 4, la OMS 5 como la EORTC 6. Como tiene un curso más indolente que los linfomas sistémicos, el linfoma primario cutáneo B ha sido considerado como un linfoma cutáneo específico desde finales de la década de 1980 7. Sin embargo, no es reconocido por la OMS como una entidad definida hasta el año 2001 8. La clasificación de la EORTC 6 siempre se ha esforzado en identificar los distintos tipos de linfomas, atendiendo a las características clínicas (curso clínico, respuesta al tratamiento), histológicas, inmunofenotípicas y genotípicas para facilitar un correcto tratamiento del paciente. Aunque la clasificación de los linfomas cutáneos de la EORTC es la más utilizada en la actualidad por los dermatólogos, muchos patólogos se ciñen aún a la clasificación de las neoplasias hematopoyéticas y linfoides de la OMS 5. Afortunadamente, en fecha muy reciente, se ha publicado una clasificación de consenso clasificación de la OMS-EORTC de los linfomas cutáneos 1 que permitirá sistematizar y homogeneizar la elaboración de estudios, así como la comunicación de resultados y, fundamentalmente, unificará la actitud de los clínicos frente a entidades concretas.
En 1996, Vermeer et al 9 describieron el LPCDP como un subtipo de linfoma primario cutáneo caracterizado por la presencia de nódulos o tumores coalescentes en las piernas de pacientes mayores. Histológicamente, la mayoría de los casos presentaban un infiltrado dérmico denso compuesto principalmente por células grandes atípicas (centrocitos, centroblastos e inmunoblastos). Aunque la EORTC incluía ya este linfoma como entidad independiente en su clasificación de 1997 6, la ubicación nosológica del LPCDP ha suscitado gran controversia durante los últimos años dada la dificultad para establecer una frontera nítida con el LPCCF, con el que comparte ciertas características. Recientes hallazgos clínicos, morfológicos y genéticos apoyan que el LPCDP y el LPCCF son tipos distintos de linfomas 1. Por dicho motivo, en la nueva clasificación de la OMS-EORTC de los linfomas cutáneos se ha reconocido como una entidad propia, bajo el epígrafe de linfoma cutáneo primario de célula B tipo piernas (LPCDB-TP)1. El cambio de denominación obedece a que un número reducido de los linfomas cutáneos primarios en localizaciones diferentes a las piernas presenta un aspecto morfológico en todo similar al LPCDP, y biológicamente se comporta también como este último con una supervivencia significativamente inferior al LPCCF de similar localización 9.
El LPCDB-TP presenta un infiltrado celular denso predominantemente formado por centroblastos e inmunoblastos. De manera característica las lesiones afectan a las regiones inferiores de las piernas 1, aunque, como comentábamos con anterioridad, esporádicamente pueden aparecer lesiones con morfología y fenotipo similar en otras localizaciones anatómicas. Clínicamente se caracteriza por afectar con mayor frecuencia a pacientes mayores, sobre todo mujeres 9,10. A diferencia del grupo de los LPCCF, estos linfomas se diseminan más a menudo a otros sitios extracutáneos y tienen un peor pronóstico 9,10. Los pacientes con LPCDB-TP localizado en las piernas muestran menor supervivencia que aquéllos con LPCDB-TP ubicado en otras zonas, y la presencia de lesiones múltiples en el momento del diagnóstico es un factor mal pronóstico significativo 1,10. Según el grupo holandés y austriaco, en general los pacientes con LPCDB-TP muestran una supervivencia del 55 % a los 5 años 1.
Desde el punto de vista histopatológico, estos linfomas muestran un infiltrado difuso que a menudo alcanza el tejido celular subcutáneo. El infiltrado está compuesto por una población celular de predominio centroblástica o inmunoblástica. Las células T reactivas son relativamente escasas y a menudo están confinadas a las áreas perivasculares 1.
Los estudios inmunohistoquímicos ponen de manifiesto células B neoplásicas monotípicas sIg y cIg así como positividad para los antígenos CD20 y CD79a. A diferencia de los linfomas LPCCF, los LPCD tipo piernas, el bcl-2 se expresa de manera intensa, aun en los casos no localizados en las piernas 11,12. El bcl-6 se expresa en la mayoría de los casos, mientras que la tinción CD10 está generalmente ausente 11. A diferencia de los LPCCF, la mayoría de los LPCD tipo piernas expresan la proteína MUM-1/IRF4 13.
En los estudios genéticos no se observa la traslocación t (14,15), a pesar de presentar un bcl-2 muy positivo 1. Esto hace pensar en la implicación de otros factores. También se han identificado desequilibrios cromosómicos en más del 85 % de los LPCD tipo piernas 14, con duplicaciones en el 18q y 7p y depleciones en el 6q como hallazgos más frecuentes 14. Estudios recientes han demostrado traslocaciones que afectan a los genes del myc, bcl-6 e IgH en los LPCDB-TP, pero no en los pacientes con LPCCF con un infiltrado difuso de centrocitos de gran tamaño en el estudio histológico 15. Recientes estudios sugieren que el LPCDB-TP tiene un perfil de expresión genética de células B activado 1.
Creemos que la nueva clasificación de los linfomas cutáneos impone un avance importante en el estudio de ciertos linfomas en cuanto que separa los LPCDB-TP como un grupo susceptible de tratamiento con quimioterapia o anticuerpos anti-CD20 desde estadios iniciales 1.